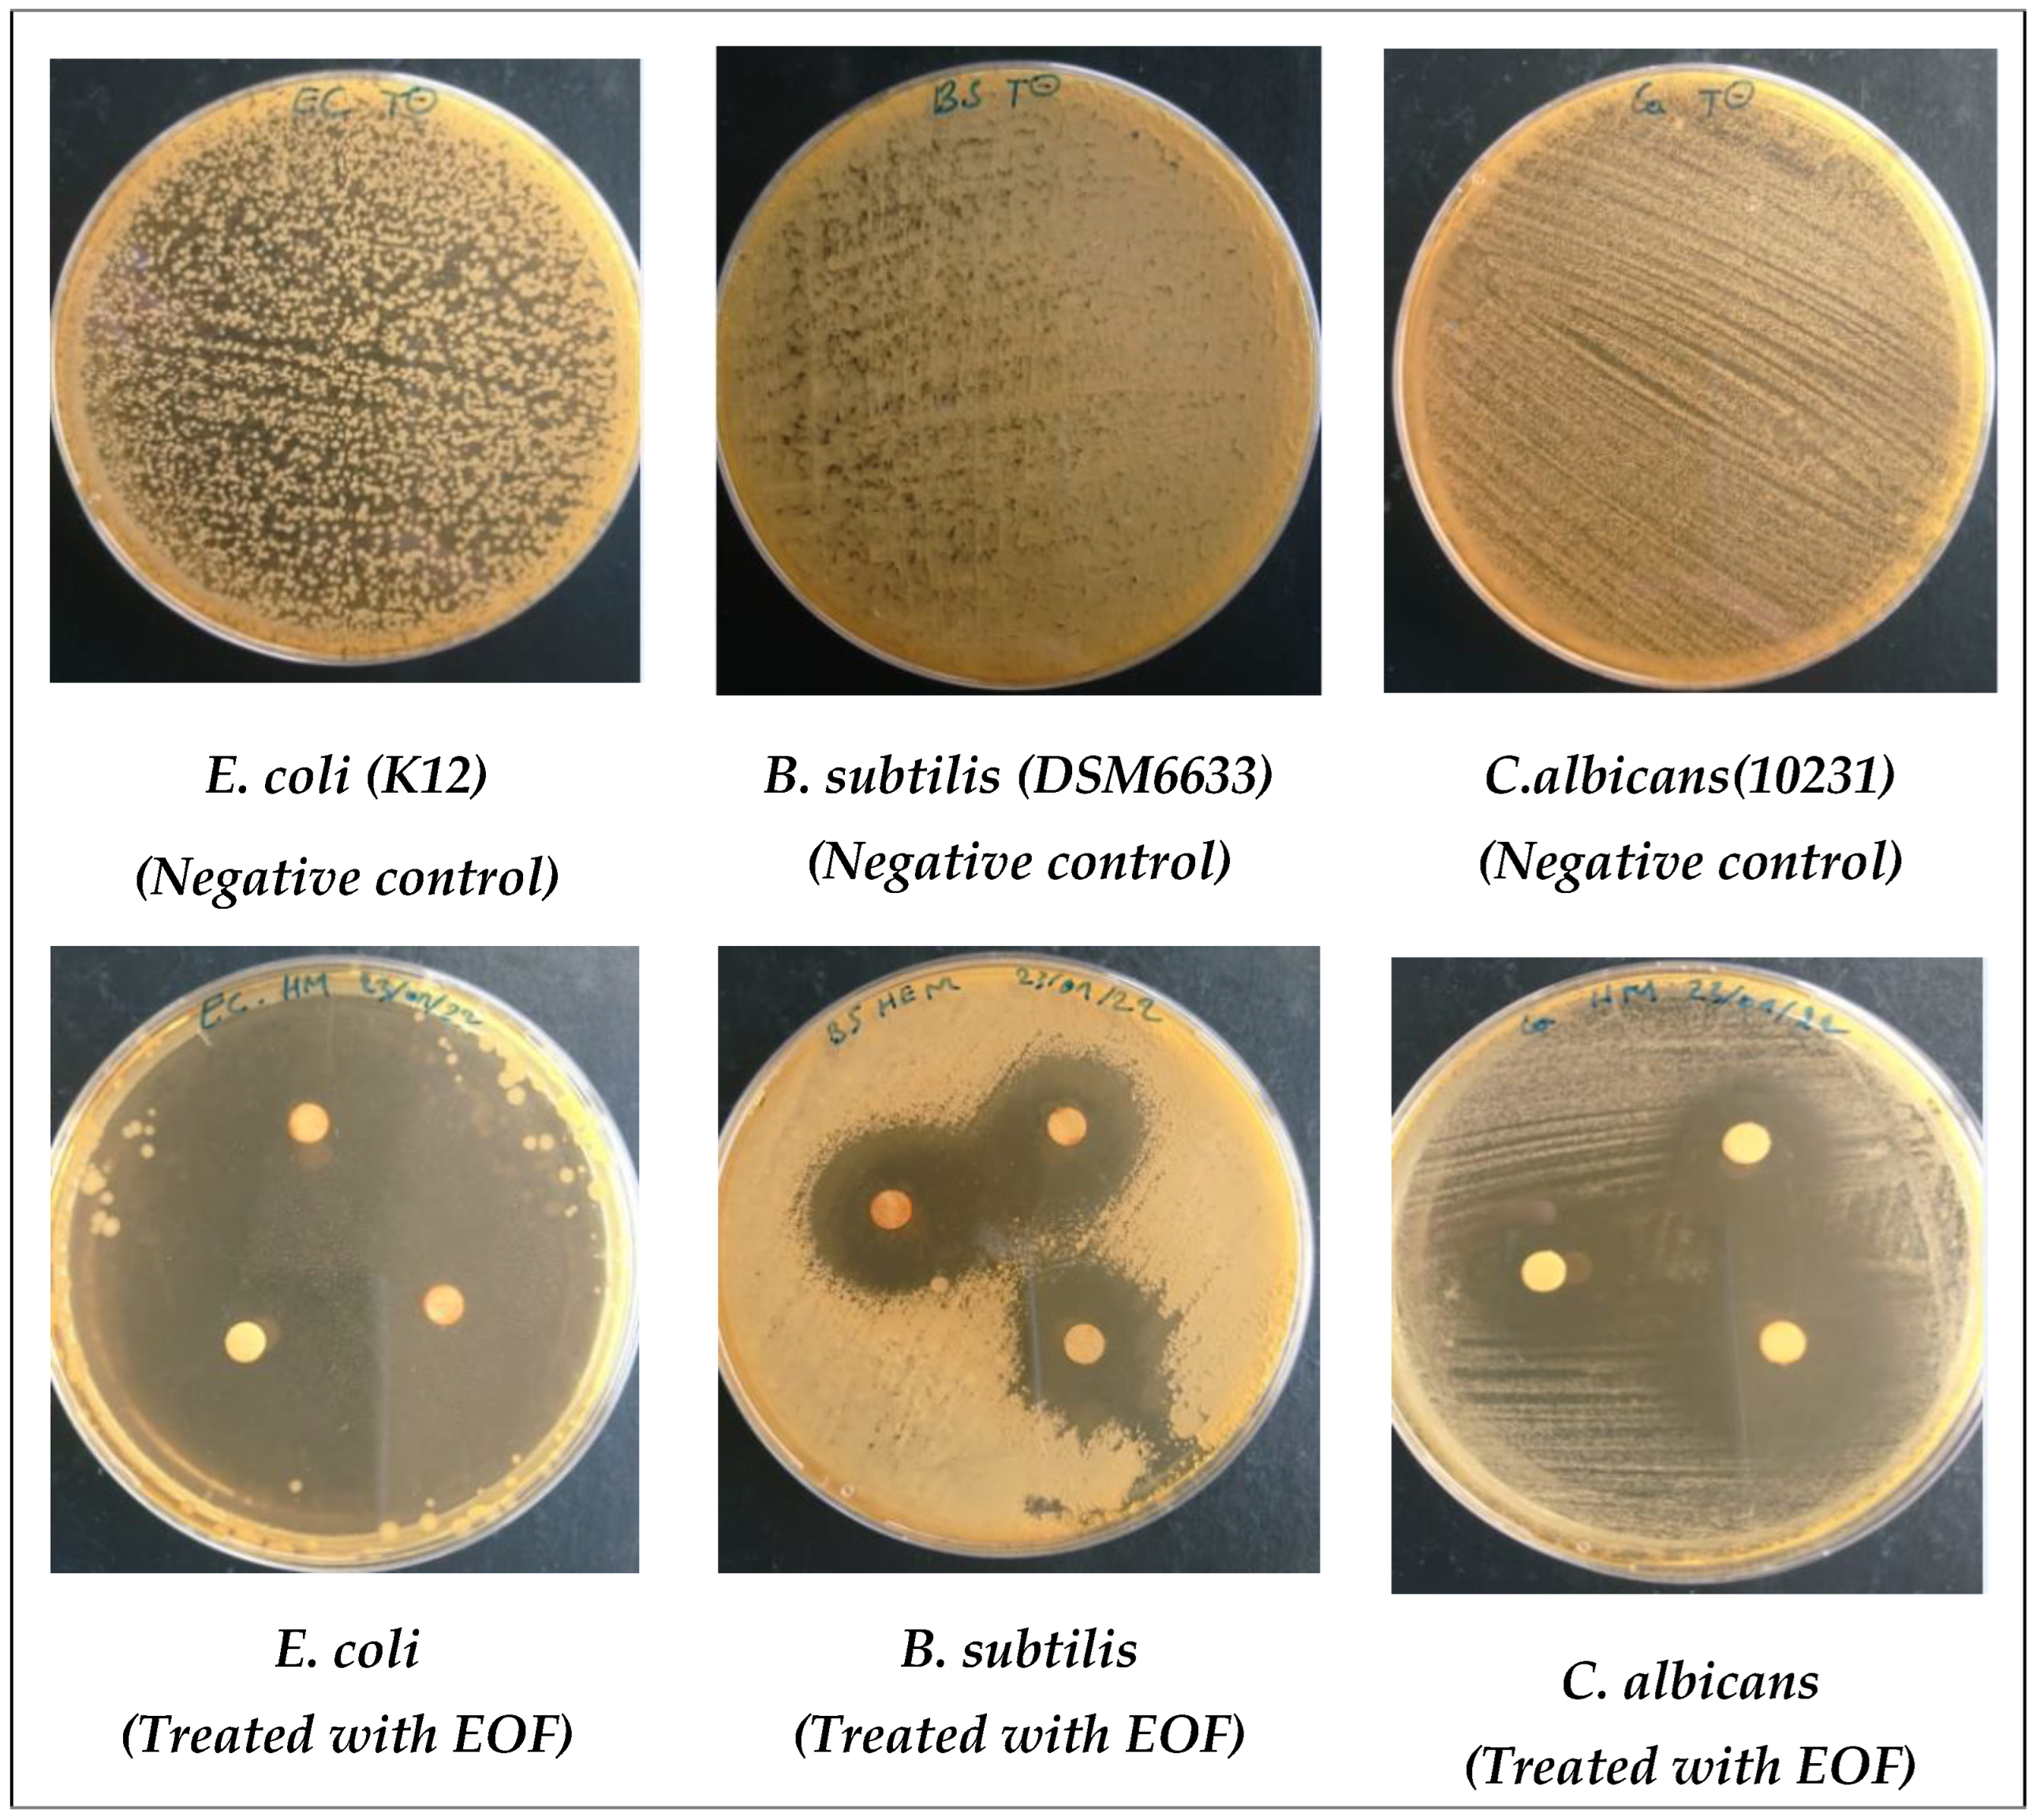
Life 13 00779 g007

In Vitro and In Silico Studies of Antimicrobial, and Antioxidant Activities of Chemically Characterized Essential Oil of Artemisia flahaultii L. (Asteraceae)
Abstract
1. Introduction
2. Materials and Methods
2.1. Reagents and Chemicals Used
2.2. Selection and Identification of Plant Material
2.3. Extraction of EOF
2.4. Analysis of the Chemical Composition of EOF by GC/MS
Gas Chromatography—Mass Spectrometry (GC/MS) Analysis
2.5. In Vitro Antioxidant Activity of EO
2.5.1. 2,2-Diphenyl-1-picrylhydrazyl Test (DPPH)
2.5.2. Ferric-Reducing Power Test (FRAP)
2.5.3. Total Antioxidant Capacity Test (TAC)
2.6. Antimicrobial Activity
2.6.1. Culture Medium
2.6.2. Strains Tested and Standardization of the Inoculum
2.6.3. Disc Diffusion Method
2.6.4. Determination of the Minimum Inhibitory Concentration (MIC)
2.7. Molecular Docking
2.8. ADME Prediction
2.9. Statistical Analysis
3. Results
3.1. Yield and Chemical Composition
3.2. Scavenger Effect of 2,2-Diphenyl-1-picrylhydrazil (DPPH)
3.3. Investigating the Total Antioxidant Capacity (TAC)
3.4. Ferric-Reducing Antioxidant Power Assay (FRAP)
3.5. Antimicrobial Activity of EOF
3.6. Molecular Docking
4. Discussion
5. Conclusions
Author Contributions
Funding
Institutional Review Board Statement
Informed Consent Statement
Data Availability Statement
Acknowledgments
Conflicts of Interest
References
- Ilie, E.T.; Kelly, S. Le Rôle des Petites et Moyennes Entreprises Agroalimentaires Dans la Transformation des Systèmes Alimentaires-Le Cas des Transformateurs de Riz Au Sénégal; Food & Agriculture Org.: Rome, Italy, 2022; Volume 10. [Google Scholar]
- Dangles, O. Le potentiel antioxydant des aliments: Mythes et réalités. Cah. Nutr. Diététique 2020, 55, 176–183. [Google Scholar] [CrossRef]
- Landecker, H. La résistance aux antibiotiques et la biologie de l’Histoire. Rev. D’anthropologie Connaiss 2021, 15. [Google Scholar] [CrossRef]
- Chebbac, K.; Moussaoui, A.E.; Bourhia, M.; Salamatullah, A.M.; Alzahrani, A.; Guemmouh, R. Chemical Analysis and Antioxidant and Antimicrobial Activity of Essential oils from Artemisia negrei L. against Drug-Resistant Microbes. Evid. Based Complement. Alternat. Med. 2021, 2021, 5902851. [Google Scholar] [CrossRef]
- Ahluwalia, V.; Sisodia, R.; Walia, S.; Sati, O.P.; Kumar, J.; Kundu, A. Chemical analysis of essential oils of Eupatorium adenophorum and their antimicrobial, antioxidant and phytotoxic properties. J. Pest Sci. 2014, 87, 341–349. [Google Scholar] [CrossRef]
- Seo, S.-M.; Kim, J.; Kang, J.; Koh, S.-H.; Ahn, Y.-J.; Kang, K.-S.; Park, I.-K. Fumigant toxicity and acetylcholinesterase inhibitory activity of 4 Asteraceae plant essential oils and their constituents against Japanese termite (Reticulitermes speratus Kolbe). Pestic. Biochem. Physiol. 2014, 113, 55–61. [Google Scholar] [CrossRef]
- Sati, S.C.; Sati, N.; Ahluwalia, V.; Walia, S.; Sati, O.P. Chemical composition and antifungal activity of Artemisia nilagirica essential oil growing in northern hilly areas of India. Nat. Prod. Res. 2013, 27, 45–48. [Google Scholar] [CrossRef] [PubMed]
- Ling, Y.; Humphries, C.; Shultz, L. Flora of China, Vol. 20 (Asteraceae); Editorial Committee, Ed.; Science Press: Beijing, China, 2006. [Google Scholar]
- Jaradat, N.; Qneibi, M.; Hawash, M.; Al-Maharik, N.; Qadi, M.; Abualhasan, M.N.; Ayesh, O.; Bsharat, J.; Khadir, M.; Morshed, R. Assessing Artemisia arborescens essential oil compositions, antimicrobial, cytotoxic, anti-inflammatory, and neuroprotective effects gathered from two geographic locations in Palestine. Ind. Crops Prod. 2022, 176, 114360. [Google Scholar] [CrossRef]
- Hinane, D.; Oubaha, S.; Satrani, B.; Ghanmi, M.; Bourkhiss, B. Domestication of the endemic plant of Morocco and high added value: Artemisia herba alba. J. Mater. Environ. Sci. 2020, 11, 283–292. [Google Scholar]
- Benouda, H.; Bouammali, B.; Challioui, A.; Oulmidi, A.; Dardouri, N. Essential oil variation in wild-growing populations of Artemisia herba-alba Asso collected from Morocco: Chemical composition and multivariate analysis. J. Mater. Environ. Sci. 2018, 9, 1741–1749. [Google Scholar]
- Ouyahya, A.; Viano, J. Contribution A L’etude Morphologique et Biometrique des Akenes de taxons Endemiques Marocaines DU Genre Artimisia. Lagascalia 1984, 8, 223–228. [Google Scholar]
- Rhanem, M. D’une haute signification biogéographique. Evaxiana 2018, 14, 364–370. [Google Scholar]
- Adams, D.R.P. Identification of Essential Oil Components by Gas Chromatography/Mass Spectrometry, 4th ed.; Wiley & Sons: New York, NY, USA, 2017; p. 811. [Google Scholar]
- Shams Moattar, F.; Sariri, R.; Yaghmaee, P.; Giahi, M. Enzymatic and Non-Enzymatic Antioxidants of Calamintha Officinalis Moench Extracts. J. Appl. Biotechnol. Rep. 2016, 3, 489–494. [Google Scholar]
- Gulluce, M.; Sahin, F.; Sokmen, M.; Ozer, H.; Daferera, D.; Sokmen, A.; Polissiou, M.; Adiguzel, A.; Ozkan, H. Antimicrobial and antioxidant properties of the essential oils and methanol extract from Mentha longifolia L. ssp. longifolia. Food Chem. 2007, 103, 1449–1456. [Google Scholar] [CrossRef]
- El Moussaoui, A.; Jawhari, F.Z.; Almehdi, A.M.; Elmsellem, H.; Fikri Benbrahim, K.; Bousta, D.; Bari, A. Antibacterial, antifungal and antioxidant activity of total polyphenols of Withania frutescens. L. Bioorganic Chem. 2019, 93, 103337. [Google Scholar] [CrossRef]
- Frazier, B.Z. Screening a Library of Chalcone Derivatives for Antibacterial Properties via Kirby Bauer Disk Diffusion. Honors Thesis, Bellarmine University, Louisville, KY, USA, 2020. [Google Scholar]
- Girija, S.A.; Priyadharsini, J.V.; Paramasivam, A. Prevalence of carbapenem-hydrolyzing OXA-type β-lactamases among Acinetobacter baumannii in patients with severe urinary tract infection. Acta Microbiol. Immunol. Hung. 2020, 67, 49–55. [Google Scholar] [CrossRef]
- Standards, N.C. Performance Standards for Antimicrobial Susceptibility Testing; Ninth Informational Supplement; M100-S9; CLSI: Malvern, PA, USA, 1999. [Google Scholar]
- Dimitrijevi, D.; Stankovi, M.; Stojanovi-Radi, Z.; Ranelovi, V.; Lakuscaron, D. Antioxidant and antimicrobial activity of different extracts from leaves and roots of Jovibarba heuffelii (Schott.) A. Löve and D. Löve. J. Med. Plants Res. 2012, 6, 4804–4810. [Google Scholar] [CrossRef]
- Ismaili, H.; Milella, L.; Fkih-Tetouani, S.; Ilidrissi, A.; Camporese, A.; Sosa, S.; Altinier, G.; Della Loggia, R.; Aquino, R. In vivo topical anti-inflammatory and in vitro antioxidant activities of two extracts of Thymus satureioides leaves. J. Ethnopharmacol. 2004, 91, 31–36. [Google Scholar] [CrossRef] [PubMed]
- Prieto, P.; Pineda, M.; Aguilar, M. Spectrophotometric Quantitation of Antioxidant Capacity through the Formation of a Phosphomolybdenum Complex: Specific Application to the Determination of Vitamin E. Anal. Biochem. 1999, 269, 337–341. [Google Scholar] [CrossRef]
- Blažeković, B.; Vladimir-Knežević, S.; Brantner, A.; Štefan, M.B. Evaluation of Antioxidant Potential of Lavandula x intermedia Emeric ex Loisel. “Budrovka”: A Comparative Study with L. angustifolia Mill. Molecules 2010, 15, 5971–5987. [Google Scholar] [CrossRef] [PubMed]
- Thomas, V.M.; Brown, R.M.; Ashcraft, D.S.; Pankey, G.A. Synergistic effect between nisin and polymyxin B against pandrug-resistant and extensively drug-resistant Acinetobacter baumannii. Int. J. Antimicrob. Agents 2019, 53, 663–668. [Google Scholar] [CrossRef] [PubMed]
- Bencheqroun, H.K.; Ghanmi, M.; Satrani, B.; Aafi, A. Activité antimicrobienne des huiles essentielles d’Artemisia mesatlantica, plante endémique du Maroc. Bull. Société R. Sci. Liège 2012, 81, 18. [Google Scholar]
- Juteau, F.; Masotti, V.; Bessière, J.M.; Dherbomez, M.; Viano, J. Antibacterial and antioxidant activities of Artemisia annua essential oil. Fitoterapia 2002, 73, 532–535. [Google Scholar] [CrossRef] [PubMed]
- Verdian, R.M.; Sadat, E.E.; Haji, A.A.; Fazeli, M.R.; Pirali, H.M. Chemical composition and antimicrobial activity of Artemisia annua L. essential oil from Iran. J. Med. Plants 2008, 7, 58–62. [Google Scholar]
- Lopes-Lutz, D.; Alviano, D.S.; Alviano, C.S.; Kolodziejczyk, P.P. Screening of chemical composition, antimicrobial and antioxidant activities of Artemisia essential oils. Phytochemistry 2008, 69, 1732–1738. [Google Scholar] [CrossRef] [PubMed]
- Akrout, A.; El Jani, H.; Amouri, S.; Neffati, M. Screening of antiradical and antibacterial activities of essential oils of Artemisia campestris L., Artemisia herba alba asso, & thymus capitatus hoff. Et link. Growing wild in the southern of Tunisia. Recent Res. Sci. Technol. 2009, 2, 29–39. [Google Scholar]
- Aicha, N.; Ines, S.; Mohamed, B.S.; Ines, B.; Soumaya, K.; Kamel, G.; Mohamed, N.; Imed, C.; Mohamed, H.; Leila, C.-G. Chemical composition, mutagenic and antimutagenic activities of essential oils from (Tunisian) Artemisia campestris and Artemisia herba-alba. J. Essent. Oil Res. 2008, 20, 471–477. [Google Scholar] [CrossRef]
- Akrout, A. Etude des huiles essentielles de quelques plantes pastorales de la région de Matmata (Tunisie). Cah. Options Méditerranéennes 2004, 62, 289–292. [Google Scholar]
- Elazzouzi, H.; Khabbal, Y.; Bouachrine, M.; Zair, T.; Alaoui El Belghiti, M. Chemical composition and in vitro antibacterial activity of Artemisia ifranensis J. Didier essential oil Growing Wild in Middle Moroccan Atlas. J. Essent. Oil Res. 2018, 30, 142–151. [Google Scholar]
- Kulisic, T.; Radonic, A.; Katalinic, V.; Milos, M. Use of different methods for testing antioxidative activity of oregano essential oil. Food Chem. 2004, 85, 633–640. [Google Scholar] [CrossRef]
- Souri, E.; Amin, G.; Farsam, H.; Jalalizadeh, H.; Barezi, S. Screening of thirteen medicinal plant extracts for antioxidant activity. Iran. J. Pharm. Res. 2022, 7, 149–154. [Google Scholar]
- Tepe, B.; Sokmen, M.; Akpulat, H.A.; Daferera, D.; Polissiou, M.; Sokmen, A. Antioxidative activity of the essential oils of Thymus sipyleus subsp. sipyleus var. sipyleus and Thymus sipyleus subsp. sipyleus var. rosulans. J. Food Eng. 2005, 66, 447–454. [Google Scholar]
- Baser, K.H.C.; Buchbauer, G. Essential Oils Science, Technology, and Applications; FLA Europe; CRC Press: Boca Raton, FL, USA, 2010; Volume 10, ISBN 9781420063165-c3. [Google Scholar]
- Chebbac, K.; Ghneim, H.K.; El Moussaoui, A.; Bourhia, M.; El Barnossi, A.; Benziane Ouaritini, Z.; Salamatullah, A.M.; Alzahrani, A.; Aboul-Soud, M.A.M.; Giesy, J.P.; et al. Antioxidant and Antimicrobial Activities of Chemically-Characterized Essential Oil from Artemisia aragonensis Lam. against Drug-Resistant Microbes. Molecules 2022, 27, 1136. [Google Scholar] [CrossRef]
- Bakkali, F.; Averbeck, S.; Averbeck, D.; Idaomar, M. Biological effects of essential oils—A review. Food Chem. Toxicol. 2008, 46, 446–475. [Google Scholar] [CrossRef] [PubMed]
- Bourhia, M.; Bouothmany, K.; Bakrim, H.; Hadrach, S.; Salamatullah, A.M.; Alzahrani, A.; Khalil Alyahya, H.; Albadr, N.A.; Gmouh, S.; Laglaoui, A.; et al. Chemical Profiling, Antioxidant, Antiproliferative, and Antibacterial Potentials of Chemically Characterized Extract of Citrullus colocynthis L. Seeds. Separations 2021, 8, 114. [Google Scholar] [CrossRef]
- Athamena, S.; Chalghem, I.; Kassah-Laouar, A.; Laroui, S.; Khebri, S. Activité antioxydante et antimicrobienne d’extraits de Cuminum cyminum L. Leban. Sci. J. 2010, 11, 69–81. [Google Scholar]
- Aouni, M.; Pelen, F.; Soulimani, R. Étude de l’activité antimicrobienne d’un mélange de 41 huiles essentielles et domaines d’application. Phytothérapie 2013, 11, 225–236. [Google Scholar] [CrossRef]
- Yu, Z.; Tang, J.; Khare, T.; Kumar, V. The alarming antimicrobial resistance in ESKAPEE pathogens: Can essential oils come to the rescue? Fitoterapia 2020, 140, 104433. [Google Scholar] [CrossRef]
- da Silva, A.R.; de Andrade Neto, J.B.; da Silva, C.R.; de Sousa Campos Campos, R.; Costa Silva, R.A.; Freitas, D.D.; do Nascimento, F.B.S.A.; de Andrade, L.N.D.; Sampaio, L.S.; Grangeiro, T.B. Berberine antifungal activity in fluconazole-resistant pathogenic yeasts: Action mechanism evaluated by flow cytometry and biofilm growth inhibition in Candida spp. Antimicrob. Agents Chemother. 2016, 60, 3551–3557. [Google Scholar] [CrossRef] [PubMed]
- Pina-Vaz, C.; Gonçalves Rodrigues, A.; Sansonetty, F.; Martinez-De-Oliveira, J.; Fonseca, A.F.; Mårdh, P.-A. Antifungal activity of local anesthetics against Candida species. Infect. Dis. Obstet. Gynecol. 2000, 8, 124–137. [Google Scholar] [CrossRef]
- Yoon, M.-A.; Jeong, T.-S.; Park, D.-S.; Xu, M.-Z.; Oh, H.-W.; Song, K.-B.; Lee, W.S.; Park, H.-Y. Antioxidant effects of quinoline alkaloids and 2, 4-di-tert-butylphenol isolated from Scolopendra subspinipes. Biol. Pharm. Bull. 2006, 29, 735–739. [Google Scholar] [CrossRef]
- Choi, S.J.; Kim, J.K.; Kim, H.K.; Harris, K.; Kim, C.-J.; Park, G.G.; Park, C.-S.; Shin, D.-H. 2, 4-Di-tert-butylphenol from sweet potato protects against oxidative stress in PC12 cells and in mice. J. Med. Food 2013, 16, 977–983. [Google Scholar] [CrossRef]
- Zhao, F.; Wang, P.; Lucardi, R.D.; Su, Z.; Li, S. Natural sources and bioactivities of 2, 4-di-tert-butylphenol and its analogs. Toxins 2020, 12, 35. [Google Scholar] [CrossRef] [PubMed]
- Boukhalkhal, S.; Gourine, N.; Pinto, D.C.; Silva, A.; Yousfi, M. Variability of the chemical composition and the antioxidant activity of the essential oils of two subspecies of Artemisia campestris L. growing in Algeria. J. Food Meas. Charact. 2018, 12, 1829–1842. [Google Scholar] [CrossRef]
- Singh, H.P.; Kaur, S.; Mittal, S.; Batish, D.R.; Kohli, R.K. In vitro screening of essential oil from young and mature leaves of Artemisia scoparia compared to its major constituents for free radical scavenging activity. Food Chem. Toxicol. 2010, 48, 1040–1044. [Google Scholar] [CrossRef] [PubMed]
- Bora, K.S.; Sharma, A. The genus Artemisia: A comprehensive review. Pharm. Biol. 2011, 49, 101–109. [Google Scholar] [CrossRef]
- El-Seedi, H.R.; El-Said, A.M.; Khalifa, S.A.; Goransson, U.; Bohlin, L.; Borg-Karlson, A.-K.; Verpoorte, R. Biosynthesis, natural sources, dietary intake, pharmacokinetic properties, and biological activities of hydroxycinnamic acids. J. Agric. Food Chem. 2012, 60, 10877–10895. [Google Scholar] [CrossRef]
- Khan, M.F.; Verma, G.; Akhtar, W.; Shaquiquzzaman, M.; Akhter, M.; Rizvi, M.A.; Alam, M.M. Pharmacophore modeling, 3D-QSAR, docking study and ADME prediction of acyl 1, 3, 4-thiadiazole amides and sulfonamides as antitubulin agents. Arab. J. Chem. 2019, 12, 5000–5018. [Google Scholar] [CrossRef]
- Uddin, M.Z.; Paul, A.; Rakib, A.; Sami, S.A.; Mahmud, S.; Rana, M.S.; Hossain, S.; Tareq, A.M.; Dutta, M.; Emran, T.B. Chemical profiles and pharmacological properties with in silico studies on elatostema papillosum wedd. Molecules 2021, 26, 809. [Google Scholar] [CrossRef]

| Flowering Stage | |
|---|---|
| Essential oil yields (%) | 0.47 |
| Color | Brown-yellow |
| Aspect | Oily |
| Peak | R.T (min) | Name | Area (%) | R.I | Chemical Classes | |
|---|---|---|---|---|---|---|
| Lit | Obs | |||||
| 1 | 7.900 | α-Pinene | 2.18 | 932 | 928 | MO.H |
| 2 | 8.638 | Benzaldehyde | 1.65 | 952 | 952 | O |
| 3 | 9.186 | β-pinène | 15.22 | 979 | 973 | MO.H |
| 4 | 10.565 | O-Cymene | 11.72 | 1026 | 1022 | MO.H |
| 5 | 10.720 | D-Limonene | 22.09 | 1024 | 1018 | MO.H |
| 6 | 10.888 | β-Ocimene, (E)- | 2.18 | 1044 | 1048 | MO.H |
| 7 | 11.593 | γ-Terpinene | 1.77 | 1059 | 1058 | MO.H |
| 8 | 13.679 | Neo-allo-ocimene | 0.62 | 1140 | 1139 | MO.H |
| 9 | 18.145 | Benzene, 2,4-pentadiynyl- | 9.04 | 1212 | 1206 | O |
| 10 | 18.720 | Cyclohexasiloxane, dodecamethyl- | 0.71 | 1243 | 1240 | O |
| 11 | 19.629 | Δ-Elemene | 3.82 | 1340 | 1335 | SQ.H |
| 12 | 20.853 | Cinnamic acid, methyl ester | 0.96 | 1452 | 1447 | MO.O |
| 13 | 21.225 | Methyleugenol | 0.93 | 1376 | 1371 | O |
| 14 | 21.897 | Caryophyllene | 0.52 | 1464 | 1464 | SQ.H |
| 15 | 23.056 | Cycloheptasiloxane, tetradecamethyl- | 0.43 | 1446 | 1447 | O |
| 16 | 23.641 | β-Selinene | 1.02 | 1490 | 1490 | SQ.H |
| 17 | 23.767 | β-Vinylnaphthalene | 10.47 | 1446 | 1439 | O |
| 18 | 23.931 | 2,4-Di-tert-butylphenol | 1.07 | 1557 | 1555 | O |
| 19 | 24.934 | Elemicin | 3.59 | 1555 | 1550 | O |
| 20 | 26.153 | Caryophyllene oxide | 2.52 | 1570 | 1567 | SQ.O |
| 21 | 26.240 | Spathulenol | 0.53 | 1578 | 1579 | SQ.O |
| 22 | 27.443 | Isospathulenol | 4.25 | 1625 | 1626 | SQ.O |
| 23 | 27.537 | Cyclooctasiloxane, hexadecamethyl- | 0.38 | 1554 | 1554 | O |
| 24 | 27.729 | Capillin | 1.56 | 1637 | 1641 | O |
| 25 | 28.226 | Ledol | 0.77 | 1602 | 1600 | SQ.O |
| Compound | Gram (−) Bacteria | Gram (+) Bacteria | Fungal Strains | ||
|---|---|---|---|---|---|
| E. coli | B. subtilis | S. aureus | F. oxysporum | C. albican | |
| EOF | 68.6 ± 1.1 a | 31.0 ± 1.0 b | 18.3 ± 1.5 c | 48.3 ± 1.5 d | 35.0 ± 0.8 b |
| Ampicillin | 10.6 ± 0.5 a | - | - | NT | NT |
| Kanamycin | - | - | - | NT | NT |
| Fluconazole | NT | NT | NT | 22.3 ±1.1 a | 32.6 ±2.5 b |
| Compound | Gram (−) Bacteria | Gram (+) Bacteria | Fungal Strains | ||
|---|---|---|---|---|---|
| E. coli | B. subtilis | S. aureus | F. oxysporum | C. albicans | |
| EOF | 1.3 ± 0.0 a | 1.7± 0.9 a | 4.4 ± 1.8 b | 10.7 ± 2.5 c | 2.23 ± 0.9 a |
| Ampicillin | 8.4 ± 0.8 a | - | - | NT | NT |
| Kanamycin | 1.8 ± 0.5 a | 2.5 ± 0.4 b | 2.2 ± 0.0 b | NT | NT |
| Fluconazole | NT | NT | NT | 2.62 ± 0.0 a | 3.82 ± 0.2 a |
| Glide G Score (Kcal/mol) | Glide E-Model (Kcal/mol) | Glide Energy (Kcal/mol) | |
|---|---|---|---|
| 2,4-Di-tert-butylphenol | −5.896 | −27.646 | −21.898 |
| Isospathulenol | −5.485 | −28.834 | −21.318 |
| Capillin | −5.436 | −34.526 | −25.391 |
| Beta-Vinylnaphthalene | −5.387 | −29.17 | −21.924 |
| O-Cymene | −5.344 | −23.239 | −17.415 |
| Elemicin | −4.961 | −38.333 | −29.49 |
| γ-terpinene | −4.906 | −24.602 | −18.813 |
| Benzaldehyde | −4.65 | −24.218 | −18.527 |
| Spathulenol | −4.508 | −24.42 | −19.062 |
| β-Selinene | −4.492 | −16.319 | −13.148 |
| Cinnamic acid, methyl ester | −4.471 | −32.984 | −25.141 |
| Benzene, 2,4-pentadiynyl- | −4.43 | −28.246 | −22.272 |
| Caryophyllene | −4.343 | −11.897 | −11.633 |
| Caryophyllene oxide | −4.144 | −19.805 | −18.17 |
| α-Pinene | −4.09 | −13.27 | −10.049 |
| D-Limonene | −4.02 | −16.575 | −14.119 |
| Methyleugenol | −3.896 | −28.648 | −23.187 |
| Ledol | −3.663 | −15.216 | −13.583 |
| Neo-allo-ocimene | −3.272 | −19.08 | −16.142 |
| δ-Elemene | −3.108 | −11.06 | −11.65 |
| β-Pinene | −2.819 | −9.574 | −8.187 |
| Cycloheptasiloxane, tetradecamethyl | −2.582 | −32.429 | −28.287 |
| (E)-β-Ocimene−1 | −2.207 | −17.529 | −16.436 |
| Compound Name | MM a | Donors HB b | Acceptors HB c | SASA d | QPlogPo/w e | QPlogBB f | QPlogS g | %Human Oral Absorption h |
|---|---|---|---|---|---|---|---|---|
| Ledol | 222.4 | 1 | 0.75 | 460.5 | 4.0 | −4.15 | 0.33 | 100 |
| Capillin | 168.2 | 0 | 2 | 441.4 | 2.8 | −3.14 | −0.10 | 100 |
| Cyclooctasiloxane Hexadecamethyl | 593.2 | 0 | 1.6 | 947.9 | 11.8 | −10.7 | −0.48 | 100 |
| Isospathulenol | 220.3 | 1 | 0.75 | 454.2 | 3.7 | −4.03 | 0.21 | 100 |
| Spathulenol | 220.3 | 1 | 0.75 | 464.7 | 3.9 | −4.23 | 0.25 | 100 |
| Caryophyllene oxide | 220.3 | 0 | 2 | 431.0 | 2.5 | −4.33 | 0.09 | 100 |
| Elemicin | 208.2 | 0 | 2.25 | 465.8 | 2.9 | −3.93 | −0.08 | 100 |
| 2,4-Di-tert-butylphenol | 206.3 | 1 | 0.75 | 467.5 | 3.8 | −3.91 | 0.12 | 100 |
| β-Vinylnaphthalene | 154.2 | 0 | 0 | 386.4 | 4.1 | −4.3 | 0.321 | 100 |
| β-Selinene | 204.4 | 0 | 0 | 464.7 | 5.3 | −6.34 | 1.01 | 100 |
| Methyleugenol | 178.2 | 0 | 1.5 | 426.9 | 2.9 | −3.77 | 0.10 | 100 |
| Cinnamic acid methyl ester | 162.2 | 0 | 2 | 414.7 | 2.4 | −2.47 | −0.20 | 100 |
| δ-Elemene | 204.4 | 0 | 0 | 472.9 | 5.5 | −6.56 | 1.01 | 100 |
| Benzene, 2,4-pentadiynyl- | 140.2 | 0.5 | 0 | 397.3 | 4.0 | −3.41 | 0.36 | 100 |
| Neo-allo-ocimene | 136.2 | 0 | 0 | 425.9 | 4.6 | −4.80 | 0.93 | 100 |
| GAMMA-TERPINENE | 136.2 | 0 | 0 | 394.3 | 4.1 | −4.16 | 0.85 | 100 |
| (E)-β-Ocimene | 136.2 | 0 | 0 | 412.2 | 4.4 | −4.69 | 0.88 | 100 |
| D-Limonene | 136.2 | 0 | 0 | 386.5 | 4.0 | −4.00 | 0.83 | 100 |
| O-Cymene | 134.2 | 0 | 0 | 373.7 | 3.7 | −4.04 | 0.64 | 100 |
| β-Pinene | 136.2 | 0 | 0 | 361.5 | 3.5 | −4.02 | 0.86 | 100 |
| Benzaldehyde | 106.1 | 0 | 2 | 300.0 | 1.5 | −1.10 | −0.08 | 94 |
| α-Pinene | 136.2 | 0 | 0 | 367.3 | 3.6 | −4.02 | 0.87 | 100 |
Disclaimer/Publisher’s Note: The statements, opinions and data contained in all publications are solely those of the individual author(s) and contributor(s) and not of MDPI and/or the editor(s). MDPI and/or the editor(s) disclaim responsibility for any injury to people or property resulting from any ideas, methods, instructions or products referred to in the content. |
© 2023 by the authors. Licensee MDPI, Basel, Switzerland. This article is an open access article distributed under the terms and conditions of the Creative Commons Attribution (CC BY) license (https://creativecommons.org/licenses/by/4.0/).
Share and Cite
Chebbac, K.; Benziane Ouaritini, Z.; El Moussaoui, A.; Chebaibi, M.; Salamatullah, A.M.; Lafraxo, S.; Bourhia, M.; Giesy, J.P.; Aboul-Soud, M.A.M.; Guemmouh, R. In Vitro and In Silico Studies of Antimicrobial, and Antioxidant Activities of Chemically Characterized Essential Oil of Artemisia flahaultii L. (Asteraceae). Life 2023, 13, 779. https://doi.org/10.3390/life13030779
Chebbac K, Benziane Ouaritini Z, El Moussaoui A, Chebaibi M, Salamatullah AM, Lafraxo S, Bourhia M, Giesy JP, Aboul-Soud MAM, Guemmouh R. In Vitro and In Silico Studies of Antimicrobial, and Antioxidant Activities of Chemically Characterized Essential Oil of Artemisia flahaultii L. (Asteraceae). Life. 2023; 13(3):779. https://doi.org/10.3390/life13030779
Chicago/Turabian StyleChebbac, Khalid, Zineb Benziane Ouaritini, Abdelfattah El Moussaoui, Mohamed Chebaibi, Ahmad Mohammad Salamatullah, Soufyane Lafraxo, Mohammed Bourhia, John P. Giesy, Mourad A. M. Aboul-Soud, and Raja Guemmouh. 2023. "In Vitro and In Silico Studies of Antimicrobial, and Antioxidant Activities of Chemically Characterized Essential Oil of Artemisia flahaultii L. (Asteraceae)" Life 13, no. 3: 779. https://doi.org/10.3390/life13030779
APA StyleChebbac, K., Benziane Ouaritini, Z., El Moussaoui, A., Chebaibi, M., Salamatullah, A. M., Lafraxo, S., Bourhia, M., Giesy, J. P., Aboul-Soud, M. A. M., & Guemmouh, R. (2023). In Vitro and In Silico Studies of Antimicrobial, and Antioxidant Activities of Chemically Characterized Essential Oil of Artemisia flahaultii L. (Asteraceae). Life, 13(3), 779. https://doi.org/10.3390/life13030779

